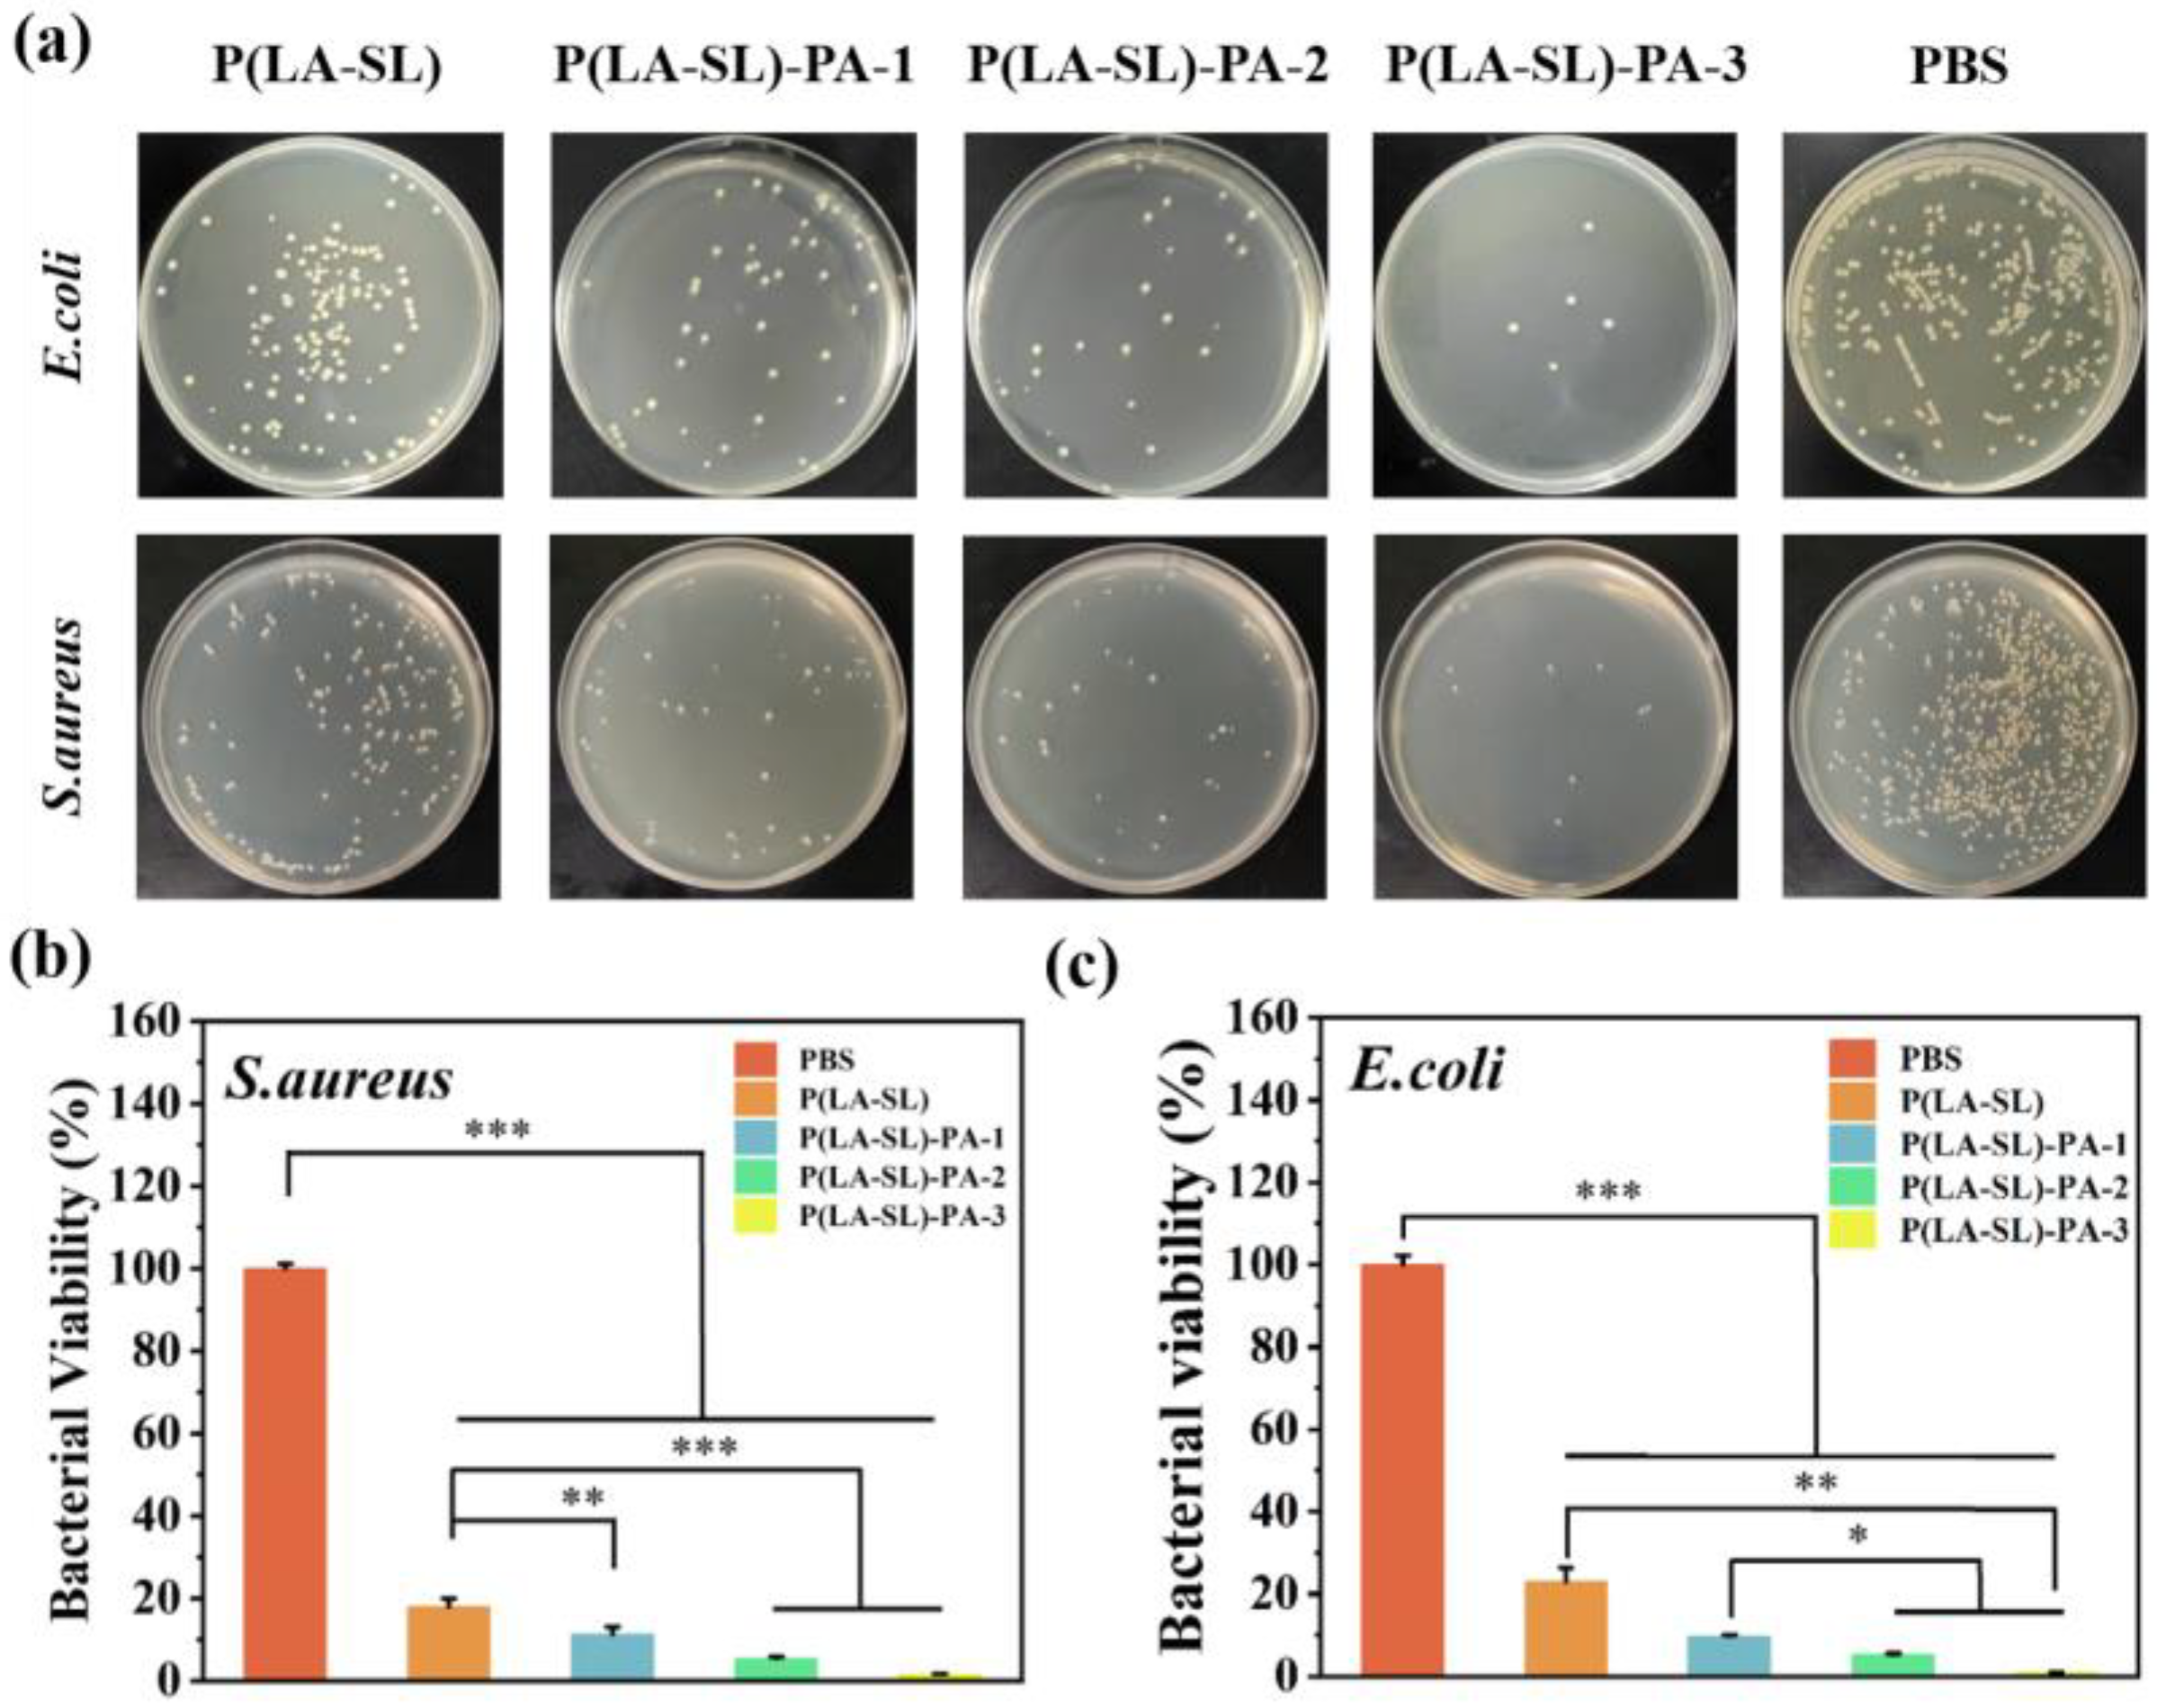
Polymers 16 01316 g006

An Injectable, Self-Healing, Adhesive Multifunctional Hydrogel Promotes Bacteria-Infected Wound Healing
Abstract
:1. Introduction
2. Materials and Methods
2.1. Materials
2.2. Preparation of P(LA-SL) Hydrogel
2.3. Preparation of P(LA-SL)-PA Hydrogels
2.4. Characterization of Hydrogels
2.5. Mechanical Characterization of Hydrogels
2.6. Rheological Test
2.7. Self-Healing Characterization of Hydrogels
2.8. Injectable Performance of Hydrogels
2.9. Adhesiveness of Hydrogels
2.10. Hemolysis Test
2.11. Cytotoxicity Assay
2.12. Antibacterial Test
2.13. In Vivo Wound Healing
2.14. Histological Analysis of Wound
2.15. Statistical Analysis
3. Results
3.1. Preparation and Characterization of Hydrogels
3.2. Injectability, Self-Healing Ability, Adhesion and Conductivity
3.3. Hemocompatibility and Cytocompatibility
3.4. Antibacterial Property
3.5. In Vivo Wound Healing Evaluation and Histological Analysis
4. Conclusions
Supplementary Materials
Author Contributions
Funding
Institutional Review Board Statement
Data Availability Statement
Acknowledgments
Conflicts of Interest
Appendix A




References
- Trompette, A.; Ubags, N.D. Skin barrier immunology from early life to adulthood. Mucosal Immunol. 2023, 16, 194–207. [Google Scholar] [CrossRef] [PubMed]
- Schafer, M.; Werner, S. Oxidative stress in normal and impaired wound repair. Pharmacol. Res. 2008, 58, 165–171. [Google Scholar] [CrossRef] [PubMed]
- Serwecińska, L. Antimicrobials and Antibiotic-Resistant Bacteria: A Risk to the Environment and to Public Health. Water 2020, 12, 3313. [Google Scholar] [CrossRef]
- Bertsch, P.; Diba, M.; Mooney, D.J.; Leeuwenburgh, S.C.G. Self-Healing Injectable Hydrogels for Tissue Regeneration. Chem. Rev. 2022, 123, 834–873. [Google Scholar] [CrossRef] [PubMed]
- Liu, P.; Jin, K.; Wong, W.; Wang, Y.; Liang, T.; He, M.; Li, H.; Lu, C.; Tang, X.; Zong, Y.; et al. Ionic liquid functionalized non-releasing antibacterial hydrogel dressing coupled with electrical stimulation for the promotion of diabetic wound healing. Chem. Eng. J. 2021, 415, 129025. [Google Scholar] [CrossRef]
- Zhao, H.; Huang, J.; Li, Y.; Lv, X.; Zhou, H.; Wang, H.; Xu, Y.; Wang, C.; Wang, J.; Liu, Z. ROS-scavenging hydrogel to promote healing of bacteria infected diabetic wounds. Biomaterials 2020, 258, 120286. [Google Scholar] [CrossRef]
- Walker, B.W.; Portillo Lara, R.; Mogadam, E.; Hsiang Yu, C.; Kimball, W.; Annabi, N. Rational design of microfabricated electroconductive hydrogels for biomedical applications. Prog. Polym. Sci. 2019, 92, 135–157. [Google Scholar] [CrossRef] [PubMed]
- Li, J.; Zhai, Y.-N.; Xu, J.-P.; Zhu, X.-Y.; Yang, H.-R.; Che, H.-J.; Liu, C.-K.; Qu, J.-B. An injectable collagen peptide-based hydrogel with desirable antibacterial, self-healing and wound-healing properties based on multiple-dynamic crosslinking. Int. J. Biol. Macromol. 2024, 259, 129006. [Google Scholar] [CrossRef]
- Li, Z.; Li, G.; Xu, J.; Li, C.; Han, S.; Zhang, C.; Wu, P.; Lin, Y.; Wang, C.; Zhang, J.; et al. Hydrogel Transformed from Nanoparticles for Prevention of Tissue Injury and Treatment of Inflammatory Diseases. Adv. Mater. 2022, 34, 2109178. [Google Scholar] [CrossRef]
- Díaz-Marín, C.D.; Zhang, L.; Lu, Z.; Alshrah, M.; Grossman, J.C.; Wang, E.N. Kinetics of Sorption in Hygroscopic Hydrogels. Nano Lett. 2022, 22, 1100–1107. [Google Scholar] [CrossRef]
- Suneetha, M.; Rao, K.M.; Han, S.S. Cell/Tissue Adhesive, Self-Healable, Biocompatible, Hemostasis, and Antibacterial Hydrogel Dressings for Wound Healing Applications. Adv. Mater. Interfaces 2022, 9, 2102369. [Google Scholar] [CrossRef]
- Bao, Z.; Gu, Z.; Xu, J.; Zhao, M.; Liu, G.; Wu, J. Acid-responsive composite hydrogel platform with space-controllable stiffness and calcium supply for enhanced bone regeneration. Chem. Eng. J. 2020, 396, 125353. [Google Scholar] [CrossRef]
- Min, Y.; Han, R.; Li, G.; Wang, X.; Chen, S.; Xie, M.; Zhao, Z. The pH-Sensitive Optical Fiber Integrated CMCS-PA@Fe Hydrogels for Photothermal Therapy and Real-Time Monitoring of Infected Wounds. Adv. Funct. Mater. 2023, 33, 2212803. [Google Scholar] [CrossRef]
- Yan, X.; Fang, W.-W.; Xue, J.; Sun, T.-C.; Dong, L.; Zha, Z.; Qian, H.; Song, Y.-H.; Zhang, M.; Gong, X.; et al. Thermoresponsive in Situ Forming Hydrogel with Sol–Gel Irreversibility for Effective Methicillin-Resistant Staphylococcus aureus Infected Wound Healing. ACS Nano 2019, 13, 10074–10084. [Google Scholar] [CrossRef] [PubMed]
- Qiao, L.; Liang, Y.; Chen, J.; Huang, Y.; Alsareii, S.A.; Alamri, A.M.; Harraz, F.A.; Guo, B. Antibacterial conductive self-healing hydrogel wound dressing with dual dynamic bonds promotes infected wound healing. Bioact. Mater. 2023, 30, 129–141. [Google Scholar] [CrossRef] [PubMed]
- Huang, Y.; Liu, D.; Guo, R.; Wang, B.; Lu, Y. Intelligent Jellyfish-type Janus Nanoreactor Targeting Synergistic Treatment of Bacterial Infections. ACS Appl. Bio Mater. 2023, 6, 2384–2393. [Google Scholar] [CrossRef] [PubMed]
- Xie, M.; Zeng, Y.; Wu, H.; Wang, S.; Zhao, J. Multifunctional carboxymethyl chitosan/oxidized dextran/sodium alginate hydrogels as dressing for hemostasis and closure of infected wounds. Int. J. Biol. Macromol. 2022, 219, 1337–1350. [Google Scholar] [CrossRef] [PubMed]
- Zeng, Q.; Qian, Y.; Huang, Y.; Ding, F.; Qi, X.; Shen, J. Polydopamine nanoparticle-dotted food gum hydrogel with excellent antibacterial activity and rapid shape adaptability for accelerated bacteria-infected wound healing. Bioact. Mater. 2021, 6, 2647–2657. [Google Scholar] [CrossRef] [PubMed]
- Li, Y.; Zheng, H.; Liang, Y.; Xuan, M.; Liu, G.; Xie, H. Hyaluronic acid-methacrylic anhydride/polyhexamethylene biguanide hybrid hydrogel with antibacterial and proangiogenic functions for diabetic wound repair. Chin. Chem. Lett. 2022, 33, 5030–5034. [Google Scholar] [CrossRef]
- Zhu, S.; Dai, Q.; Yao, L.; Wang, Z.; He, Z.; Li, M.; Wang, H.; Li, Q.; Gao, H.; Cao, X. Engineered multifunctional nanocomposite hydrogel dressing to promote vascularization and anti-inflammation by sustained releasing of Mg2+ for diabetic wounds. Compos. Part B Eng. 2022, 231, 109569. [Google Scholar] [CrossRef]
- Koehler, J.; Brandl, F.P.; Goepferich, A.M. Hydrogel wound dressings for bioactive treatment of acute and chronic wounds. Eur. Polym. J. 2018, 100, 1–11. [Google Scholar] [CrossRef]
- Hamedi, H.; Moradi, S.; Hudson, S.M.; Tonelli, A.E. Chitosan based hydrogels and their applications for drug delivery in wound dressings: A review. Carbohydr. Polym. 2018, 199, 445–460. [Google Scholar] [CrossRef] [PubMed]
- Chen, C.; Yang, X.; Li, S.-J.; Zhang, C.; Ma, Y.-N.; Ma, Y.-X.; Gao, P.; Gao, S.-Z.; Huang, X.-J. Tannic acid–thioctic acid hydrogel: A novel injectable supramolecular adhesive gel for wound healing. Green Chem. 2021, 23, 1794–1804. [Google Scholar] [CrossRef]
- Babaluei, M.; Mojarab, Y.; Mottaghitalab, F.; Farokhi, M. Injectable hydrogel based on silk fibroin/carboxymethyl cellulose/agarose containing polydopamine functionalized graphene oxide with conductivity, hemostasis, antibacterial, and anti-oxidant properties for full-thickness burn healing. Int. J. Biol. Macromol. 2023, 249, 126051. [Google Scholar] [CrossRef] [PubMed]
- Liang, Y.; Li, Z.; Huang, Y.; Yu, R.; Guo, B. Dual-Dynamic-Bond Cross-Linked Antibacterial Adhesive Hydrogel Sealants with On-Demand Removability for Post-Wound-Closure and Infected Wound Healing. ACS Nano 2021, 15, 7078–7093. [Google Scholar] [CrossRef] [PubMed]
- Zhang, X.; Tan, B.; Wu, Y.; Zhang, M.; Liao, J. A Review on Hydrogels with Photothermal Effect in Wound Healing and Bone Tissue Engineering. Polymers 2021, 13, 2100. [Google Scholar] [CrossRef] [PubMed]
- Liu, X.; Zhang, Y.; Liu, Y.; Hua, S.; Meng, F.; Ma, Q.; Kong, L.; Pan, S.; Che, Y. Injectable, self-healable and antibacterial multi-responsive tunicate cellulose nanocrystals strengthened supramolecular hydrogels for wound dressings. Int. J. Biol. Macromol. 2023, 240, 124365. [Google Scholar] [CrossRef] [PubMed]
- Du, J.; Wang, F.; Li, J.; Yang, Y.; Guo, D.; Zhang, Y.; Yang, A.; He, X.; Cheng, Y. Green polymer hydrogels from a natural monomer with inherent antioxidative capability for efficient wound healing and spinal cord injury treatment. Biomater. Sci. 2023, 11, 3683–3694. [Google Scholar] [CrossRef]
- Wang, F.; Du, J.; Qiao, H.; Liu, D.; Guo, D.; Chen, J.; Zhang, Y.; Cheng, Y.; He, X. Natural small molecule-induced polymer hydrogels with inherent antioxidative ability and conductivity for neurogenesis and functional recovery after spinal cord injury. Chem. Eng. J. 2023, 466, 143071. [Google Scholar] [CrossRef]
- Yang, H.; Shen, W.; Liu, W.; Chen, L.; Zhang, P.; Xiao, C.; Chen, X. PEGylated Poly(α-lipoic acid) Loaded with Doxorubicin as a pH and Reduction Dual Responsive Nanomedicine for Breast Cancer Therapy. Biomacromolecules 2018, 19, 4492–4503. [Google Scholar] [CrossRef]
- Yang, X.; Zhang, B.; Li, J.; Shen, M.; Liu, H.; Xu, X.; Shang, S. Self-healing, self-adhesive, and stretchable conductive hydrogel for multifunctional sensor prepared by catechol modified nanocellulose stabilized poly(α-thioctic acid). Carbohydr. Polym. 2023, 313, 120813. [Google Scholar] [CrossRef]
- Chai, C.; Zhang, P.; Ma, L.; Fan, Q.; Liu, Z.; Cheng, X.; Zhao, Y.; Li, W.; Hao, J. Regenerative antibacterial hydrogels from medicinal molecule for diabetic wound repair. Bioact. Mater. 2023, 25, 541–554. [Google Scholar] [CrossRef]
- Zheng, W.; Li, Y.; Xu, L.; Huang, Y.; Jiang, Z.; Li, B. Highly stretchable, healable, sensitive double-network conductive hydrogel for wearable sensor. Polymer 2020, 211, 123095. [Google Scholar] [CrossRef]
- Kumar, A.; Singh, B.; Raigond, P.; Sahu, C.; Mishra, U.N.; Sharma, S.; Lal, M.K. Phytic acid: Blessing in disguise, a prime compound required for both plant and human nutrition. Food Res. Int. 2021, 142, 110193. [Google Scholar] [CrossRef]
- Jin, S.; Li, K.; Zhang, X.; Gao, Q.; Zeng, L.; Shi, S.Q.; Li, J. Phytic acid-assisted fabrication for soybean meal/nanofiber composite adhesive via bioinspired chelation reinforcement strategy. J. Hazard. Mater. 2020, 399, 123064. [Google Scholar] [CrossRef]
- Feizollahi, E.; Mirmahdi, R.S.; Zoghi, A.; Zijlstra, R.T.; Roopesh, M.S.; Vasanthan, T. Review of the beneficial and anti-nutritional qualities of phytic acid, and procedures for removing it from food products. Food Res. Int. 2021, 143, 110284. [Google Scholar] [CrossRef]
- Zhang, Q.; Liu, X.; Zhang, J.; Duan, L.; Gao, G. A highly conductive hydrogel driven by phytic acid towards a wearable sensor with freezing and dehydration resistance. J. Mater. Chem. A 2021, 9, 22615–22625. [Google Scholar] [CrossRef]
- Zhang, X.; Li, L.; Ouyang, J.; Zhang, L.; Xue, J.; Zhang, H.; Tao, W. Electroactive electrospun nanofibers for tissue engineering. Nano Today 2021, 39, 101196. [Google Scholar] [CrossRef]
- Wang, Z.; Ma, Z.; Wang, S.; Pi, M.; Wang, X.; Li, M.; Lu, H.; Cui, W.; Ran, R. Cellulose nanocrystal/phytic acid reinforced conductive hydrogels for antifreezing and antibacterial wearable sensors. Carbohydr. Polym. 2022, 298, 120128. [Google Scholar] [CrossRef]
- Wang, Y.; Garcia, C.R.; Ding, Z.; Gabrilska, R.; Rumbaugh, K.P.; Wu, J.; Liu, Q.; Li, W. Adhesive, Self-Healing, and Antibacterial Chitosan Hydrogels with Tunable Two-Layer Structures. ACS Sustain. Chem. Eng. 2020, 8, 18006–18014. [Google Scholar] [CrossRef]
- Shao, X.-H.; Yang, X.; Zhou, Y.; Xia, Q.-C.; Lu, Y.-P.; Yan, X.; Chen, C.; Zheng, T.-T.; Zhang, L.-L.; Ma, Y.-N.; et al. Antibacterial, wearable, transparent tannic acid–thioctic acid–phytic acid hydrogel for adhesive bandages. Soft Matter 2022, 18, 2814–2828. [Google Scholar] [CrossRef] [PubMed]
- Wang, Y.; Yang, M.; Zhao, Z. Facile fabrication of self-healing, injectable and antimicrobial cationic guar gum hydrogel dressings driven by hydrogen bonds. Carbohydr. Polym. 2023, 310, 120723. [Google Scholar] [CrossRef] [PubMed]
- Cui, C.; Mei, L.; Wang, D.; Jia, P.; Zhou, Q.; Liu, W. A self-stabilized and water-responsive deliverable coenzyme-based polymer binary elastomer adhesive patch for treating oral ulcer. Nat. Commun. 2023, 14, 7707. [Google Scholar] [CrossRef] [PubMed]
- Jin, P.; Xia, M.; Hasany, M.; Feng, P.; Bai, J.; Gao, J.; Zhang, W.; Mehrali, M.; Wang, R. A tough injectable self-setting cement-based hydrogel for noninvasive bone augmentation. Interdiscip. Mater. 2023, 2, 771–788. [Google Scholar] [CrossRef]
- Chen, J.; He, J.; Yang, Y.; Qiao, L.; Hu, J.; Zhang, J.; Guo, B. Antibacterial adhesive self-healing hydrogels to promote diabetic wound healing. Acta Biomater. 2022, 146, 119–130. [Google Scholar] [CrossRef]
- Zhang, X.; Feng, J.; Feng, W.; Xu, B.; Zhang, K.; Ma, G.; Li, Y.; Yang, M.; Xu, F.-J. Glycosaminoglycan-Based Hydrogel Delivery System Regulates the Wound Microenvironment to Rescue Chronic Wound Healing. ACS Appl. Mater. Interfaces 2022, 14, 31737–31750. [Google Scholar] [CrossRef]

Disclaimer/Publisher’s Note: The statements, opinions and data contained in all publications are solely those of the individual author(s) and contributor(s) and not of MDPI and/or the editor(s). MDPI and/or the editor(s) disclaim responsibility for any injury to people or property resulting from any ideas, methods, instructions or products referred to in the content. |
© 2024 by the authors. Licensee MDPI, Basel, Switzerland. This article is an open access article distributed under the terms and conditions of the Creative Commons Attribution (CC BY) license (https://creativecommons.org/licenses/by/4.0/).
Share and Cite
Zhang, L.; Wang, Y.; Yang, M.; Yu, W.; Zhao, Z.; Liu, Y. An Injectable, Self-Healing, Adhesive Multifunctional Hydrogel Promotes Bacteria-Infected Wound Healing. Polymers 2024, 16, 1316. https://doi.org/10.3390/polym16101316
Zhang L, Wang Y, Yang M, Yu W, Zhao Z, Liu Y. An Injectable, Self-Healing, Adhesive Multifunctional Hydrogel Promotes Bacteria-Infected Wound Healing. Polymers. 2024; 16(10):1316. https://doi.org/10.3390/polym16101316
Chicago/Turabian StyleZhang, Ling, Yan Wang, Mingrui Yang, Wen Yu, Zheng Zhao, and Yichao Liu. 2024. "An Injectable, Self-Healing, Adhesive Multifunctional Hydrogel Promotes Bacteria-Infected Wound Healing" Polymers 16, no. 10: 1316. https://doi.org/10.3390/polym16101316




